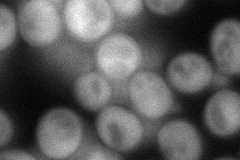
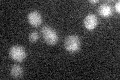

View description
Putative protein of unknown function; subunit of the ASTRA complex (Rvb1p, Rvb2p, Tra1p, Tti1p, Tti2, Asa1p and Tra1p) which is part of the chromatin remodeling machinery
Localization:
Intensity:
Fold change:
Significance:
-
C’ GFP library in SD

below threshold16.57 -
N' NOP1pr-GFP in SD
cytosol84.5623 -
N' TEF2pr-mCherry in SD

cell periphery,vacuole115.752 -
N' NATIVEpr-GFP in SD

below threshold14.8331 -
N' TEF2pr-VC and Cyto-VN in SD

#N/A0 -
C’ GFP library in SD+DTT

cytosol17.811.07No -
C’ GFP library in SD+H2O2

cytosol171.02No -
C’ GFP library in Starvation Media
cytosol18.431.11No -
C’ GFP library on the background of Pup2-DaMP

below threshold -
C’ GFP library on the background of CCT mutant

below threshold16.44330.991483No
